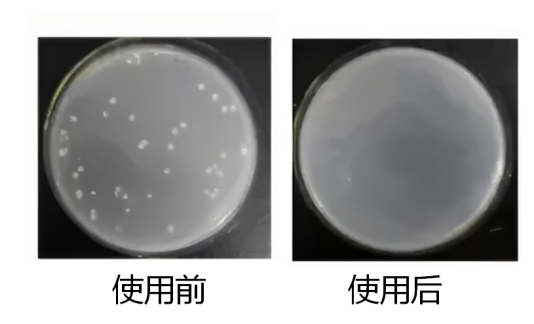
细胞房安全卫士   1.png

相关产品推荐更多 >
万千商家帮你免费找货
0 人在求购买到急需产品
- 详细信息
- 文献和实验
- 技术资料
- 库存:
9999
- 英文名:
EV-Room SafeGuard
- 规格:
480 mL
产品简介
细胞培养过程中,污染是一件令研究人员头疼的事情。在细胞污染源中,研究人员往往忽略了来自细胞房的细菌及真菌等污染。为了保持细胞房的无菌环境,逸微健华推出了细胞房安全卫士,本产品具有很强的抑菌功能,可用于细胞房的污染控制,通过清除细胞房内细菌、真菌及其孢子,可有效防止细胞的污染,从而减少由于细胞污染带来的人力和物力的浪费。
产品用途
用于实验环境的细菌、真菌清除和抑制。
产品特点
高效稳定:高效清除细胞房死角、墙面、地板的细菌以及紫外线杀灭不了真菌及其孢子,清除率接近100%。
安全环保:无毒、无味、无挥发性,可以取代84、甲醛等毒性处理方法。
产品数据
图1.结果显示,用本产品后抑菌效果明显
风险提示:丁香通仅作为第三方平台,为商家信息发布提供平台空间。用户咨询产品时请注意保护个人信息及财产安全,合理判断,谨慎选购商品,商家和用户对交易行为负责。对于医疗器械类产品,请先查证核实企业经营资质和医疗器械产品注册证情况。
文献和实验Asepsis and Aseptic Practices in the Operating Room
Preventing surgical site infection in the operating room is the primary goal of the surgical team, and all activities performed by the team support this goal. Some of these activities include patient risk assessment, environmental cleaning
相关专题 一、 常规操作 1. 穿着专用实验服。自己的白大衣或厚外套,可脱在门外的衣帽架上。 2. 穿着专用拖鞋。在缓冲间换下自己的鞋子,尽量避免在缓冲间走动、停留。 3. 细胞房最多可4个人同时使用。尽量避免在内长时间逗留、交谈。 二、 培养箱使用规则 1. 从培养箱取放物品前,用酒精清洁双手(或手套),尽量缩短开门时间和减少开门次数。 * 培养箱中的空气是经过过滤的洁净空气。长时间敞开
Reversible, Room Temperature Bonding of Glass Devices for Microfluidics
This chapter describes a procedure for bonding glass microdevice substrates to their top plates by contact alone. This method results in devices that are robustly bonded but that can be separated, cleaned, and reused. For glass











